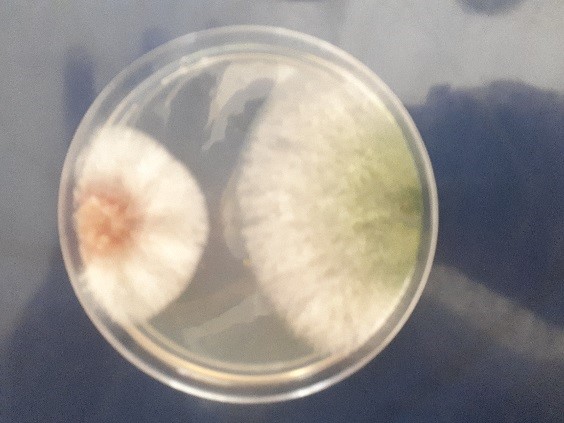

با همت عضو هیات علمی بخش تحقیقات گیاهپزشکی مرکز؛
پروژه "جهشیافتههای قارچ تریکودرما و مبارزه با پژمردگی فوزاریومی خیار"
تحولی نوین در کنترل بیماریهای گیاهی

به گزارش روابط عمومی مرکز تحقیقات و آموزش کشاورزی و منابع طبیعی گیلان؛ پروژه تحقیقاتی با محوریت افزایش کارایی قارچ تریکودرما در بیوکنترل بیماریهای گیاهی و تحمل تنشهای محیطی، مراحل نهایی خود را طی میکند.
این پژوهش که با همکاری پژوهشکده کشاورزی هستهای و به سرپرستی سیدرضا فانی، عضو هیات علمی بخش تحقیقات گیاهپزشکی این مرکز؛ در حال اجراست، بر بررسی جهشیافتههای این قارچ مفید تمرکز دارد.
در این تحقیق، بهترین جهشیافتههای قارچ تریکودرما به منظور افزایش تأثیرگذاری در کنترل پژمردگی فوزاریومی خیار با والد وحشی مقایسه شدهاند. تریکودرما به عنوان یک عامل بیولوژیکی مهم با تولید آنزیمهایی چون سلولاز، کیتیناز و بتاگلوکاناز، نقش مؤثری در تخریب دیواره سلولی بیمارگرها و تقویت ایمنی گیاهان دارد.
مطالعات نشان دادهاند که پرتودهی گاما میتواند تولید این آنزیمها را افزایش دهد.
در بازه زمانی ۱۴۰۱-۱۴۰۲، ۱۰۰ نمونه خاک از ریزوسفر گیاهان مختلف جمعآوری شد که منجر به جداسازی ۲۴ جدایه قارچ تریکودرما گردید. پس از آزمایشهای مختلف، جدایه منتخب از طریق روشهای مولکولی شناسایی شد و برای افزایش توانایی تولید آنزیمهای بیوکنترلی، تحت تابش گاما قرار گرفت.
از میان ۱۲۰ جهشیافته حاصل، دو مورد توانستند عملکرد مطلوبی در کنترل بیماری و تحمل شرایط نامساعد نشان دهند.
جهت دریافت اخبار در کانال ایتای سازمان کلیک نمایید.
جهت دریافت اخبار در کانال ایتای مرکز کلیک نمایید.